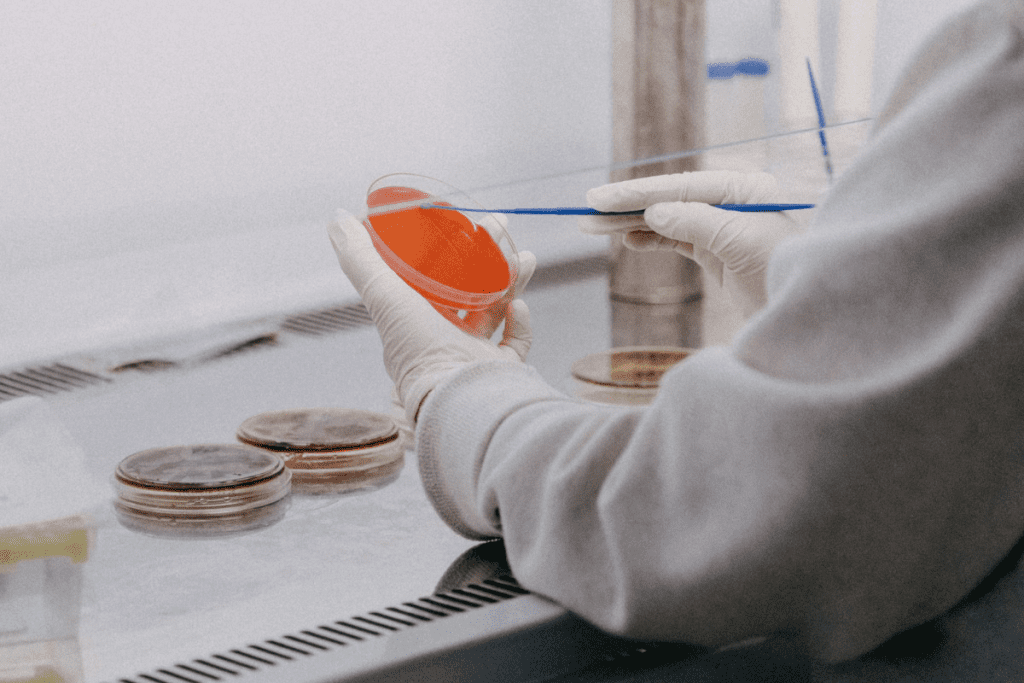
Extending Life: The Best Link Between Gene Therapy and reverse aging in mice 2 Extending Life: The Link Between Gene Therapy and reverse aging in mice

Last Updated on October 20, 2025 by

We are on the brink of a major breakthrough in reverse aging in mice research. Recent studies have shown that gene therapy can greatly extend life and health in animals. A key 2024 study found that using OSK genes increased mice’s median lifespan by up to 109%. It also improved their frailty scores.
As a leading healthcare provider, we aim to bring life-changing treatments to our patients. The potential of gene therapy to change human longevity is huge. We’re eager to delve deeper into its possibilities.
Key Takeaways
- Gene therapy has shown promise in extending lifespan and improving healthspan in animal models.
- A 2024 study achieved a 109% increase in median lifespan in mice using OSK genes.
- Partial cellular reprogramming improved frailty scores in mice.
- Gene therapy may have significant implications for human longevity.
- We are committed to exploring and delivering innovative treatments.
The Science Behind Gene Therapy and Aging
Gene therapy is key to fighting aging. It targets aging’s genetic roots. Recent mouse studies show it’s promising.
Understanding the Genetic Basis of Aging
Aging is complex, influenced by genes, environment, and lifestyle. Some genes control aging and age-related diseases. For example, OSK genes help reverse cell aging.
Cellular reprogramming uses these genes to turn adult cells into stem cells. These stem cells can become different cell types. This method has reversed aging in mice, boosting their health and life span.
How Gene Therapy Targets Age-Related Decline
Gene therapy tackles aging by fixing its genetic causes. It uses genes like OSK to make cells younger. Studies show this can greatly improve mice’s health and life span.
For instance, using OSK genes can extend mice’s life by 109%. It rejuvenates cells and tissues, enhancing health and lowering disease risk.
“The ability to reprogram cells to a younger state has significant implications for our understanding of aging and age-related diseases. It opens up new avenues for the development of therapeutic interventions aimed at improving healthspan and lifespan.”
Gene therapy’s potential to fight aging is huge. Ongoing research aims to apply these mouse findings to humans. As we delve deeper into gene therapy and aging, we’re learning how it can enhance human health.
Landmark Discoveries in Reverse Aging in Mice
Recent breakthroughs in gene therapy have led to significant advancements in reversing aging in mice. These discoveries have opened new avenues for understanding the complex processes involved in aging. They show how these processes can be manipulated to extend lifespan and improve healthspan.

OSK Gene Reprogramming: 109% Lifespan Extension
A 2024 study showed that OSK gene reprogramming increased median remaining lifespan in mice by 109%. This finding highlights the potential of gene therapy in addressing age-related decline. The OSK gene reprogramming technique reprograms cells to a more youthful state, rejuvenating tissues and organs.
The study’s implications are significant. It suggests that similar approaches could be developed for humans in the future. By understanding how OSK gene reprogramming achieves such dramatic lifespan extension, researchers can explore new targets for anti-aging therapies.
The Role of Partial Cellular Reprogramming
Partial cellular reprogramming partially reprograms cells to a more youthful state without losing their identity. This method has shown promise in age reversal technology. It rejuvenates cells and tissues without the risks of full reprogramming.
Research has shown that partial cellular reprogramming can lead to significant improvements in healthspan and lifespan in mice. Scientists aim to develop therapies to combat age-related diseases in humans using this technique.
The study of reverse aging on mice continues to provide valuable insights into the aging process and potential interventions. As research progresses, the hope is that these findings will translate into effective treatments for humans. This could lead to a longer and healthier life.
The s-KL Protein: A Promising Target for Longevity
The s-KL protein is seen as a key player in the search for longer life. It has been studied a lot, showing its potential in aging research. This protein might help us live longer.
2025 Research Findings on s-KL Protein Therapy
Recent studies, including a big 2025 research, have shown s-KL protein therapy’s promise. This therapy uses the s-KL protein to make cells and tissues younger. It could help us live longer.
15-20% Lifespan Extension in Mouse Models
The 2025 study showed s-KL protein therapy can extend mouse lifespans by 15-20%. This is a big deal because it shows s-KL protein therapy could help us live longer.
Breakthroughs in mouse reverse aging studies give us hope for human longevity. The age reversal in mouse models helps us understand aging better. They show us how to tackle aging in humans.
OSER1 Gene: Cross-Species Life Extension Potential
The OSER1 gene is seen as a key player in the fight against aging. Studies have shown its effects in many species. This gives us new views on how aging works.
Multi-Species Validation of OSER1’s Effects
Research on the OSER1 gene shows it can help extend life in different species. This is important for understanding its role in aging. It also hints at its use in humans.
Key findings include:
- Significant lifespan extension in mouse models
- Positive effects on healthspan, improving overall health and quality of life
- Conserved mechanisms across species, indicating potential applicability to humans
Cellular Mechanisms Behind OSER1’s Longevity Benefits
The OSER1 gene affects many cellular processes linked to longevity. Knowing these mechanisms is key for making gene therapies work.
Some of the key cellular mechanisms include:
- Enhanced cellular stress resistance
- Improved DNA repair mechanisms
- Regulation of cellular senescence
By focusing on these mechanisms, OSER1 gene therapy could help us age better. It could also extend our lifespan in different species.
From Healthspan to Lifespan: Quality vs. Quantity of Life
The difference between healthspan and lifespan is key to understanding gene therapy’s effect on aging. Lifespan is about how long we live. Healthspan is about how well we live those years, focusing on being healthy.
Gene therapy could improve both how long and how well we live. It’s important to see how it can enhance our health and life span.
Defining Healthspan vs. Lifespan
Healthspan and lifespan are closely linked but different in aging studies. Lifespan is just how long we live. Healthspan is the time we stay healthy, without serious illness or disability.
Gene therapy has shown to increase lifespan in animals like mice. For example, age reversing in mice has been achieved through genetic changes.
How Gene Therapy Improves Quality of Life Metrics
Gene therapy could make our lives better by fixing age-related problems. It targets genes linked to aging. This can boost physical health, reduce frailty, and improve overall happiness.
- Improving cellular function through genetic reprogramming
- Enhancing mitochondrial function to reduce oxidative stress
- Promoting cellular renewal and reducing senescence
Studies on reversing aging in mice show gene therapy can greatly improve healthspan. This means animals can live longer and healthier.
In summary, gene therapy could change how we live and age. By understanding healthspan and lifespan, and using gene therapy, we aim for a future where we live longer and better.
Human Gene Therapy Trials: Current Progress
Recent breakthroughs in gene therapy have marked a significant leap in human clinical trials. We are entering a new era in treating diseases, including blood disorders, with innovative gene therapy methods.
Exagamglogene Autotemcel for Blood Disorders
Exagamglogene autotemcel is a promising gene therapy for blood disorders. It has shown robust improvements in the quality of life for patients with certain genetic blood conditions. This therapy aims to modify the patient’s genes to address the root cause of these disorders.
Clinical trials with exagamglogene autotemcel have shown great promise. Patients with severe blood disorders have seen better health outcomes, needing fewer medical interventions. Studies, like those on PMC, suggest gene therapy is becoming a viable treatment option.
Quality of Life Improvements in Clinical Settings
The impact of gene therapy on patients’ quality of life is significant. By targeting genetic causes, gene therapy offers the chance for long-term health improvements. In clinical settings, therapies like exagamglogene autotemcel have led to:
- Reduced hospital visits
- Improved overall health and well-being
- Better management of disease symptoms
As we move forward in gene therapy, it’s vital to keep track of ongoing clinical trials. The data from these trials will guide the future of gene therapy and its use in treating various diseases.
Challenges in Translating Mouse Studies to Human Applications
Gene therapy has shown great promise in mice. But, moving it to humans is a big challenge. Mouse studies have reversed aging, but applying this to humans needs careful thought.
Biological Differences Between Mice and Humans
Mice and humans share a lot of their genes. Yet, their biology and aging are different. Mice live shorter lives and have different metabolism than humans. These differences impact how gene therapy works in humans.
Key biological differences include:
- Genetic makeup and expression
- Metabolic rates and pathways
- Lifespan and aging processes
- Immune system responses
Safety Concerns and Regulatory Hurdles
Safety and regulatory hurdles are also big hurdles. Making sure gene therapy is safe for humans requires strict clinical trials. These trials must check for side effects, immune reactions, and long-term effects.
Regulatory bodies like the FDA have strict rules. They ensure gene therapies are safe for humans. This includes preclinical tests and phased clinical trials in humans.
Key regulatory considerations include:
- Preclinical testing for safety and efficacy
- Phased clinical trials to assess human response
- Ongoing monitoring for long-term effects
- Compliance with regulatory guidelines
As we continue with gene therapy research, tackling these challenges is key. It will help us unlock gene therapy’s full potential for human longevity.
The Future Landscape of Gene Therapy for Longevity
Gene therapy is set to change aging research a lot. We’re seeing big steps forward in how we fight age-related diseases. This change is exciting and full of promise.
“The possibilities are endless,” says a top researcher. “Gene therapy could fix the aging problem at its source, not just treat symptoms.” Many studies show it works well in reversing aging mice and making them live longer.
Emerging Targets and Combination Approaches
Scientists are looking into new targets for gene therapy. They’re also trying out combining gene therapy with other treatments. For example, mixing it with senolytic therapy seems to work better in age reversal in mice studies.
New tech like CRISPR/Cas9 gene editing is also being tested. Experts say it could change gene therapy by making precise edits to aging genes.
Personalized Gene Therapy Based on Individual Genetics
Personalized gene therapy is another exciting area. It’s made just for you based on your genes. Doctors can look at your genes to find out why you’re aging.
Then, they can create a gene therapy plan just for you. It targets the genes and pathways that affect your aging. As “Personalized gene therapy could change longevity research. It lets us give treatments that really fit what each person needs.”
Looking ahead, gene therapy will be key in aging research. With new targets, ways to mix treatments, and personalized plans, we’re on the edge of a new era in aging research.
Conclusion: Will Gene Therapy Revolutionize Human Longevity?
Gene therapy has shown great promise in making animals live longer and healthier. Studies on mice have been especially encouraging. They have shown that mice can live much longer than before.
We see gene therapy as a key to changing how we age. It targets specific genes and proteins to help us age better. While there are still hurdles to overcome, we’re excited about the possibilities. We aim to bring these treatments to our patients to improve their lives.
We’ll keep an eye on the latest in gene therapy and its use in aging. Our goal is to stay ahead in medical science. This way, we can offer our patients the best treatments available.
FAQ
What is gene therapy and how does it work?
Gene therapy is a medical treatment that uses genes to prevent or treat diseases. It targets the genetic basis of aging. Genes like OSK reprogram cells to a younger state, reversing age-related decline.
What is the OSK gene and how does it contribute to reverse aging in mice?
The OSK gene is a mix of genes that reprogram cells to a younger state. This reverses age-related decline. Studies show OSK can extend a mouse’s lifespan by up to 109%.
What is the s-KL protein and its role in longevity research?
The s-KL protein is a key target in longevity research. Therapy using this protein can extend a mouse’s lifespan by 15-20%.
What is the OSER1 gene and its potential for cross-species life extension?
The OSER1 gene is a promising candidate for life extension across species. Research has shown its longevity benefits in multiple species.
How does gene therapy improve healthspan and lifespan?
Gene therapy can improve both healthspan and lifespan. Healthspan is the quality of life, while lifespan is its length. Gene therapy can enhance overall well-being.
What is the current status of human gene therapy trials?
Human gene therapy trials are ongoing with promising results. Trials using exagamglogene autotemcel for blood disorders have shown significant quality of life improvements for patients.
What are the challenges in translating mouse studies to human applications?
Translating mouse studies to humans is complex. Biological differences and safety concerns must be addressed. Regulatory hurdles also need to be overcome.
What is the future of gene therapy for longevity?
Gene therapy for longevity is rapidly evolving. New targets and combination approaches are being explored. Personalized gene therapy based on individual genetics is also being developed.
Can gene therapy reverse aging in humans?
Gene therapy has shown promise in extending lifespan and improving healthspan in animal models. Its potential to reverse aging in humans is still being researched and tested in clinical trials.
What is the difference between lifespan and healthspan?
Lifespan is the length of life, while healthspan is the quality of life. Gene therapy aims to improve both.
Are there any safety concerns associated with gene therapy?
Yes, there are safety concerns with gene therapy. There’s a risk of adverse reactions. Careful regulation is needed to ensure safe and effective treatment.
References
- Roig-Soriano, J., et al. (2025). New anti-aging gene therapy extends lifespan by up to 20%. SciTech Daily. Retrieved from https://scitechdaily.com/new-anti-aging-gene-therapy-extends-lifespan-by-up-to-20/
- Li, Z., & Rasmussen, L. J. (2024). Newly discovered protein OSER1 found to influence longevity. Biocompare. Retrieved from https://www.biocompare.com/Life-Science-News/614793-Newly-Discovered-Protein-OSER1-Found-to-Influence-Longevity/
- de la Fuente, J., et al. (2025). Gene therapy leads to improved quality of life in patients with sickle cell disease and beta thalassemia. Blood Advances. Retrieved from https://www.hematology.org/newsroom/press-releases/2025/gene-therapy-leads-to-improved-quality-of-life